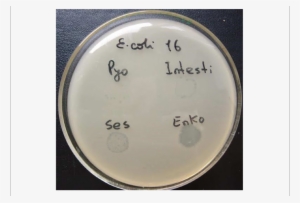
Plaque Metal Png - Bacteriophage #4202388

-
Pedal To The Metal - G052 Gel Ii
480*600
3
1
-
Petal To The Metal - China Glaze
400*398
2
1
-
Nail Art Wheel - Nail Art
1612*1623
3
1
-
Pnd Metal Led/uv Lamp 60w
802*459
3
1
-
Metal - Scary Monsters
300*573
3
1
-
Metal / Resin Pin Badge - Pin-back Button
600*313
3
1
-
Metal Blade Skull - Florida
1200*837
3
1
-
Metal Go Button - Digital Scrapbooking
456*456
3
1
-
Pendientes De Metal En Círculo - Earrings
667*500
3
1
-
Metal Gear
640*360
3
1
-
A Monotone Effect Using Grey Ink Over Grey Paper, Use
2510*1848
3
1
-
Metal Fireworks Doodle - Clarke & Clarke
456*456
3
1
-
Metal Warriors Rockets - Rockets Pack Uk
400*400
2
1
-
Abx4 High-res Image4 - Iphone
1100*1100
3
1
-
Plaque Metal Png - Bacteriophage
850*577
3
1
-
C02 Laserable Metal Plaque - Picture Frame
750*920
3
1
-
Bronze Plaque With Color Print On Metal - Bronze
379*454
3
1
-
Floor Metal Signs - Señal De Piso Mojado
1024*757
3
1
-
Security Metal Detector
600*600
2
1
-
Siddhi Equipments Analog Metal Detector
2768*3653
3
1
-
Metal Detector - Fake Minelab Gpx 5000
1151*1280
4
1
-
Metal Detector Multimeter Voltmeter - Multimeter
750*980
3
1
-
White's Coinmaster Pro Metal Detector
458*659
3
1
-
Gc1061a (md-4030)hobby Metal Detector
2924*2924
3
1
-
Garrett Ace 300 Mid Range Metal Detector
496*333
3
1
-
Doctor Who
3600*2712
4
1
-
Green Volcom Hexagon Metal Preview
360*360
4
1
-
For Metallic Steel Plate - Steel
850*409
3
1
-
<<sterling Silver>> - Locket
480*480
3
1
-
Car Alarm Metal Hand Pipe - Car
700*700
3
1
-
Quick Blow-dry Metal Nylon Round Brush - Brush
550*550
3
1
-
Rustic Metal Shelf - Shelf
4608*3456
3
1
-
Automatic Metal Mouse Trap-galvanize
409*321
3
1
-
Fettipop Metal Slinky - Spiral
2464*1632
3
1
-
Metal Santa Belt Bucket 6-in - Statistical Graphics
1949*2501
2
1
-
Metal Trinket Tray - Mehndi
500*500
2
1
-
Wonder Woman Logo Metallic - Graphic Design
844*490
4
1
-
Metal Bucket Png Clipart
6398*8000
3
1
-
Copper-filled Metal Composite Htpla
600*600
3
1
-
Metal Impact Extrusions - Impact Extrusion
960*559
3
1
-
Metal Roofing - " - Hardwood
950*712
3
1
-
Boden Metal - Black Pearl Png Hd
1066*1600
4
1